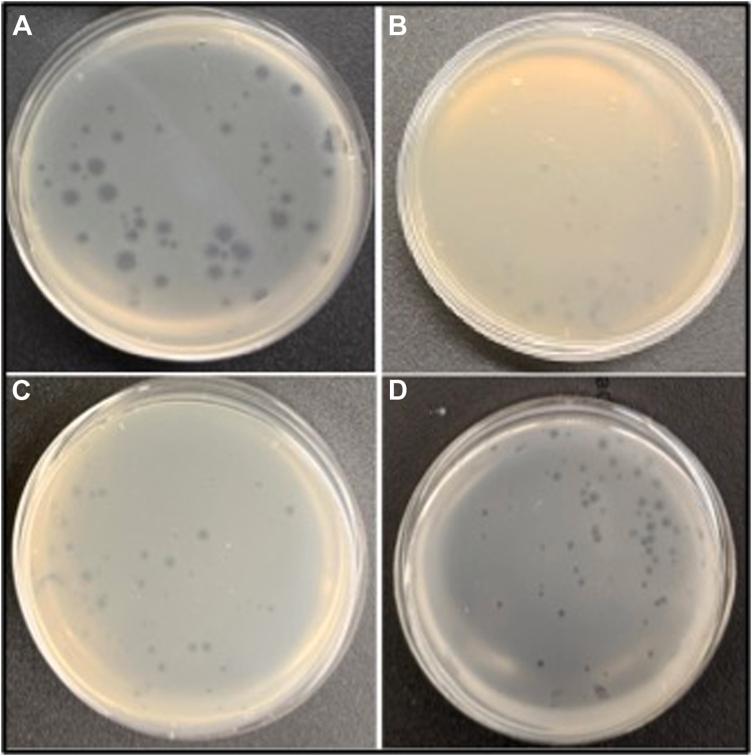
https://cdn.ncbi.nlm.nih.gov/pmc/blobs/abc1/12274811/93904f53666e/gr2.jpg

严重急性呼吸综合征冠状病毒(SARS-CoV)进入的潜在阻断剂及其刺突蛋白基序在库贝病毒平台上的狭窄功能。
Potential blocker of SARS-CoV entry and a narrow functionality of its spike protein motifs on Qubevirus platform.
作者信息
Dzelamonyuy Aristide, Ntemafack Augustin, Georgiadis Millie M, Bopda Waffo Alain
机构信息
Department of Biochemistry and Molecular Biology, Indiana University School of Medicine.
Department of Biochemistry and Molecular Biology, Indiana University School of Medicine.
出版信息
J Biol Chem. 2025 Jun 12;301(7):110371. doi: 10.1016/j.jbc.2025.110371.
Targeted disruption of SARS-CoV entry remains a critical strategy in antiviral therapeutic design. Central to this process is the viral spike (S) protein, which mediates host recognition via interactions with the human angiotensin-converting enzyme 2 (hACE2). Here, we expand our previous work by identifying the smallest active spike (S) protein binding motif (RBSM) and key residues of SARS-CoV (S) that recognize hACE2. Using the Qubevirus (Qβ) platform, we validated five essential residues (L472, N473, N479, D480, and Y491) that are critical for SARS-CoV binding and entry. Qβ phage-displayed RBSM variants disrupted hACE2 recognition and infection initiation. An engineered RBSM insert containing all five mutant residues completely abolished recognition and binding to both hACE2 and anti-RBD antibodies. Furthermore, QβRBSM1 exhibits no cytotoxic effect on HEK293T cells and reduces the infectivity of SARS-CoV pseudovirus in a competitive assay, as a blocker of SARS-CoV entry. In addition, building upon our previous studies, we determined the optimal positioning of a chimera comprising the three epitopes mapped, fused with an LPTEG/Biot-tag at the N-terminus of the Qβ-A minor coat protein for anti-S antibody titration. We determined the optimal chimera tag configuration to be epitope 3 (S) fused directly with the A at the N terminus, followed by epitope 1 (S), epitope 2 (S), and the tag at the C terminus. This work provides key insights into the druggability of the RBSM for developing SARS-CoV inhibitors and lays the foundation for designing a biosensor for antibody monitoring and a potential subunit vaccine.
靶向破坏严重急性呼吸综合征冠状病毒(SARS-CoV)的进入机制仍然是抗病毒治疗设计中的关键策略。这一过程的核心是病毒刺突(S)蛋白,它通过与人血管紧张素转换酶2(hACE2)相互作用介导宿主识别。在此,我们通过鉴定识别hACE2的SARS-CoV刺突(S)蛋白的最小活性结合基序(RBSM)和关键残基,扩展了我们之前的工作。利用Qβ噬菌体平台,我们验证了五个对SARS-CoV结合和进入至关重要的必需残基(L472、N473、N479、D480和Y491)。Qβ噬菌体展示的RBSM变体破坏了hACE2识别和感染起始。包含所有五个突变残基的工程化RBSM插入片段完全消除了对hACE2和抗RBD抗体的识别和结合。此外,QβRBSM1对人胚肾293T细胞无细胞毒性作用,并且在竞争性试验中作为SARS-CoV进入的阻断剂降低了SARS-CoV假病毒的感染性。此外,基于我们之前的研究,我们确定了一种嵌合体的最佳定位,该嵌合体包含三个已定位的表位,在Qβ-A次要衣壳蛋白的N端与LPTEG/Biot标签融合,用于抗S抗体滴定。我们确定最佳的嵌合体标签配置为表位3(S)在N端直接与A融合,随后是表位1(S)、表位2(S),标签在C端。这项工作为开发SARS-CoV抑制剂的RBSM的可药用性提供了关键见解,并为设计用于抗体监测的生物传感器和潜在的亚单位疫苗奠定了基础。